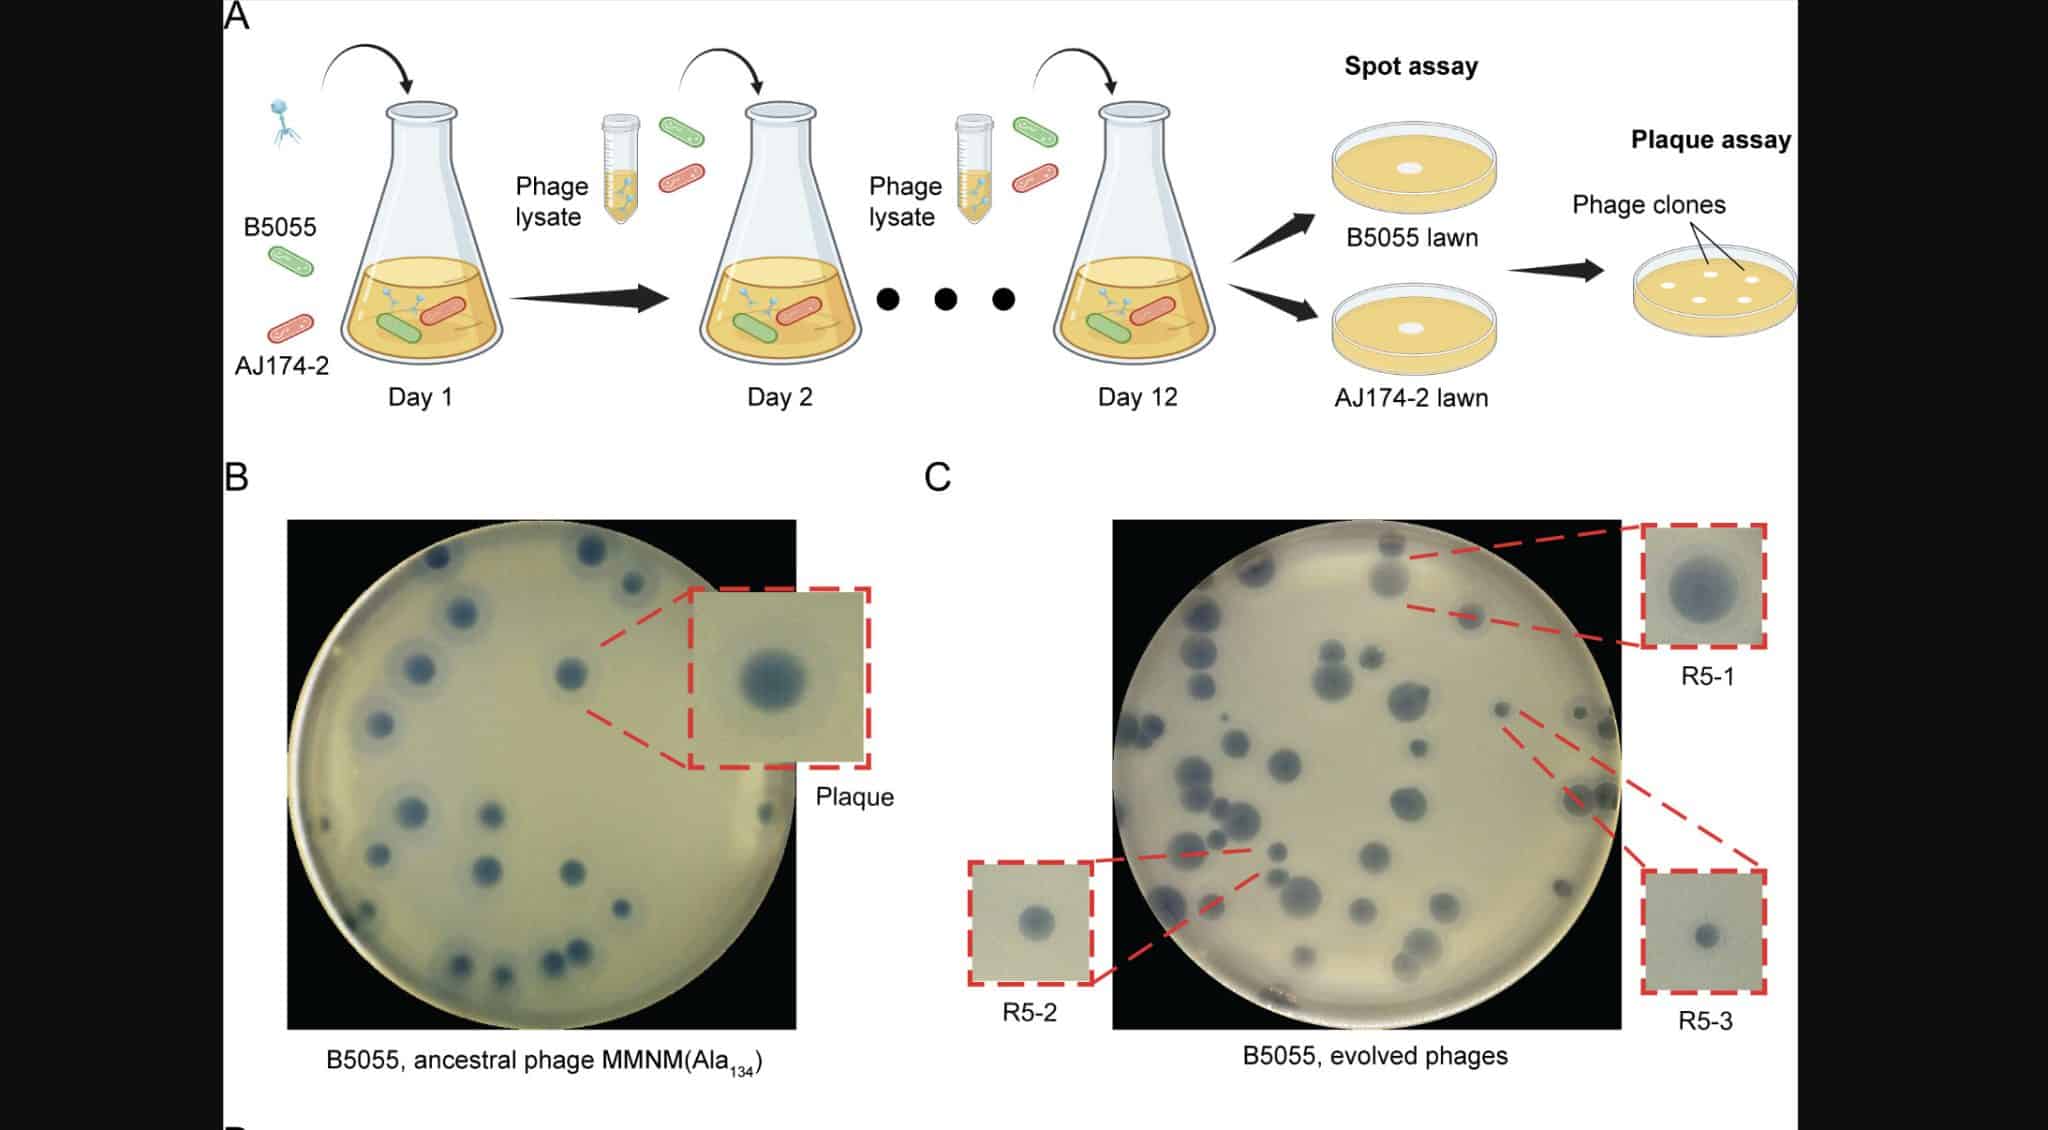
Отдельная субпопуляция фага MMNM, фаг MMNM (Ala134) / © mBio (2024).

Статьи по тегу #вирусы

Инфаркты и инсульты остаются главной причиной смертей на Земле. Новые данные указали на то, что значительная их часть провоцируется вирусом, который еще недавно считали безобидной детской болезнью. Интересно, что он …
Александр Березин
18.03.2026

Основным фактором развития плоскоклеточного рака кожи считается ультрафиолетовое излучение, которое может провоцировать в клетках генетические мутации. Американские онкологи впервые описали клинический случай, когда развитию этой формы рака способствовал вирус папилломы …
Денис Яковлев
21.08.2025

Некоторые виды рака кожи, например меланома, очень плохо поддаются лечению. Иммунотерапия рака не всегда легко переносится больными. Онкологи обнаружили, что широко распространенный и обычно безвредный цитомегаловирус может облегчить реакцию пациентов …
Денис Яковлев
24.04.2025

Бактериофаги — вирусы, которые заражают бактерии, — приобрели множество хитроумных адаптаций к жизни внутри клетки. Джамбо-фаги среди них выделяются рекордными размерами — как вирусной частицы, так и генома. Вирусы-«слоны» даже …
Михаил Орлов
09.02.2025

В недавнем отчете Центров по контролю и профилактике заболеваний США (CDC) на короткое время появилось упоминание о случаях передачи вируса птичьего гриппа H5N1 от кошек людям и наоборот. Хотя информацию …
Юлия Трепалина
07.02.2025

На территории современного Мельбурна до прихода европейцев десятки тысяч лет жили, занимаясь охотой и собирательством, племена австралийских аборигенов — Вурунтьери (Wurundjeri). Недавно в этой местности ученые из Университета Монаш (Австралия) …
Любовь Соковикова
10.11.2024
Популярные категории
Популярные статьи

Медицина
Крышка унитаза не защитила от смываемых вирусов 29.01.2024
Биология
В водных путях Вурунтьери нашли бактериофаги, убивающие супербактерии 10.11.2024
Биология
Биологи нашли способ контролировать таяние ледников с помощью гигантских вирусов 07.06.2024
Медицина
Мыши заболели птичьим гриппом, выпив сырого молока 26.05.2024
Медицина
В США опубликовали и удалили данные о возможной передаче H5N1 от кошек людям 07.02.2025
Биология
Джамбо-фаг украл у бактерии белки для своего «ядра» 09.02.2025
Медицина
Цитомегаловирус помог лечить больных раком 24.04.2025
Медицина
Распространенный вирус впервые вызвал одну из форм рака кожи 21.08.2025
Медицина
Вакцина вдвое уменьшила частоту сердечных осложнений 18.03.2026